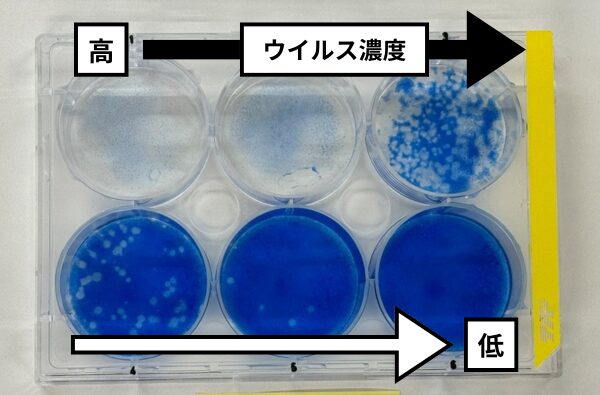
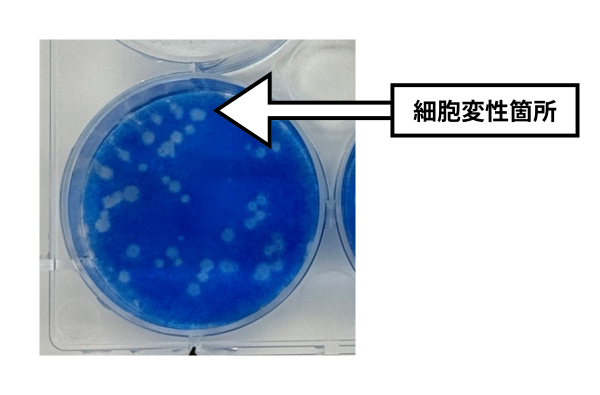

浮遊ウイルス・浮遊菌の除去性能評価試験についてご紹介!
食環研では、空気清浄機やエアコンなど、空気中のウイルスや菌に対しての効果を評価する除去性能評価試験を実施しております。
(参考規格:JEMA「空気清浄機の浮遊ウイルスに対する除去性能評価方法」2011年7月4日制定)
試験内容
食環研では、1㎥もしくは25㎥の空間にウイルスや菌を噴霧して機械を作動させた後、評価したい時点毎に空気を回収して、空気中のウイルス力価ないし菌数を測定します。
初期からの対数減少値を算出し、2.0以上(99%減少)を示すときに除去効果があるものと判断します。

※例では運転時間90分となっていますが、ご要望に応じて時間の延長ならびに短縮が可能です。
図1. 試験結果(例)

上図の場合、対照区と試験区の対数減少値の差は2.70となり、対数減少値の差2.0以上の基準を満たすため、運転時間15分で除去効果ありと判定されます。
弊社の浮遊試験場
1㎥チャンバー
1 m四方のアクリル板を組み立てて、噴霧器、ウイルス液や菌液、捕集器などをセットしてから完全に密閉し、チャンバーの外から操作します。
バイオセーフティレベル3の部屋内で実施しているため、ウイルスや菌の持ち込み、持ち出しに関しては厳重な管理を行っております。
25㎥試験室
浮遊試験で使用する様々な機材をセットできる仕様となっています。
1㎥チャンバー同様、バイオセーフティレベル3の管理基準を満たしており、安全性にも十分注意しています。


力価測定方法
弊社では、TCID50法とプラーク法の2種類の測定法を実施しております。どちらの測定法もウイルスに感染すると細胞の形状が変化する現象(細胞変性)を利用したウイルス量の測定法です。
①TCID50法
希釈したウイルス液を順番に接種した際に、希釈列の半数の細胞が感染する濃度をウイルス感染価とします。

②プラーク法
シート状に培養した細胞に希釈したウイルス液を順番に接種したあと、寒天で被い培養します。こうすることで、ウイルスの感染が隣り合った細胞のみに限定されて拡大するため、感染して細胞変性が起きた箇所を肉眼で数えることができます。

殺菌、ウイルス不活化試験なら食環境衛生研究所へ
| 試験可能なウイルス/菌 | |
|---|---|
| ウイルス | インフルエンザウイルス(H1N1)、ネコカリシウイルスなど |
| 菌 | 好気性菌(黄色ブドウ球菌、大腸菌、緑膿菌など) ※嫌気性菌は実施不可、カビは1㎥空間のみとなります。 |
